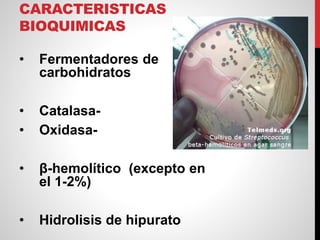
CARACTERISTICAS
BIOQUIMICAS
• Fermentadores de
carbohidratos
• Catalasa-
• Oxidasa-
• β-hemolítico (excepto en
el 1-2%)
• Hidrolisis de hipurato

Streptococcus agalactiae, también conocido como grupo B Streptococcus, es un cocobacilo Gram positivo que puede causar enfermedades graves en recién nacidos como meningitis, sepsis y neumonía. Se caracteriza por ser un fermentador de carbohidratos, catalasa- y oxidasa-, y producir hemolisis β. Coloniza asintomáticamente las vías respiratorias y genitales de adultos, y puede transmitirse a neonatos durante el parto, causando enfermedad neonatal precoz o tardía. El tratamiento de elección es la penic